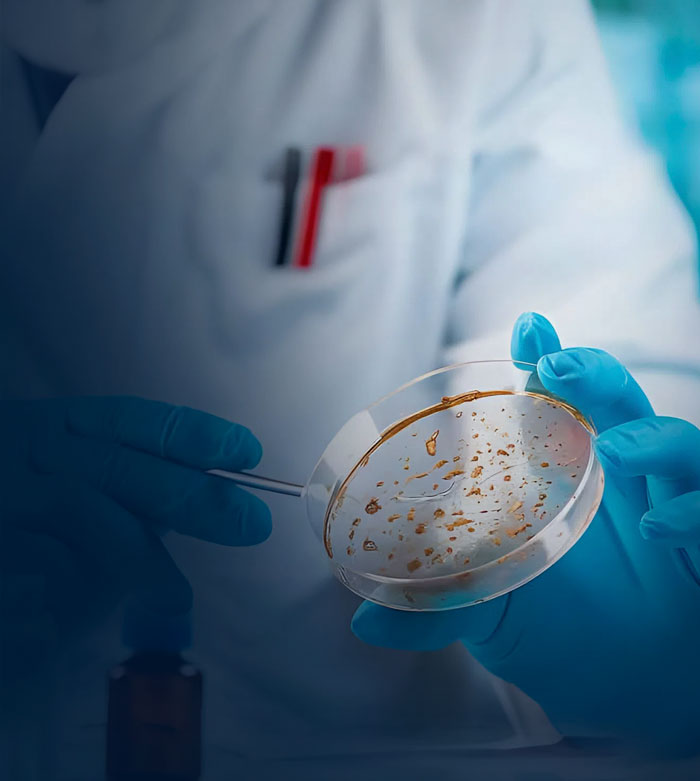

Test with Top Lab Equipment
Utilize premium laboratory equipment for testing to ensure high-quality, reliable results and enhance.
Speciality Diagnostic Centre the first and only of its kind in Irinjalakuda, established in 2006 January has the full infrastructure and facilities for carrying out Laboratory investigations uitlising the most advanced technologies in the modern diagnostic field.
More About Us
Departments

Department
of
Microbiology
Culture and Sensitivity test of a sample in progress at the department of microbiology

SEROLOGY
Serology is the study of blood serum to detect antibodies or antigens. It’s commonly used for diagnosing infections and immune responses.
IMMUNOLOGY
Immunology is the study of the immune system and its functions. It explores how the body defends itself against diseases and foreign substances.
TUMOUR MARKERS
Tumour markers are substances, often proteins, produced by cancer cells or the body in response to cancer. They help in detecting, monitoring, and managing certain types of cancers.

Speciality Diagnostic Centre
Test with Top Lab Equipment
Speciality Diagnostic Centre the first and only of its kind in Irinjalakuda, established in 2006 January has the full infrastructure and facilities for carrying out Laboratory investigations uitlising the most advanced technologies in the modern diagnostic field. We have complete Diagnostic Service Facilities including Clinical laboratory, X ray, ECG and Ultra Sound Scan and has already earned the reputation of being best staffed, best equipped and fast growing diagnostic service centre, Kerala. All the results are released after strict scrutiny by our Quality Control Team. Our qualified technical staffs are well trained and they ensure stringent quality control for all the diagnostic services.
Speciality Diagnostic Centre
Test with Top Lab Equipment
Speciality Diagnostic Centre the first and only of its kind in Irinjalakuda, established in 2006 January has the full infrastructure and facilities for carrying out Laboratory investigations uitlising the most advanced technologies in the modern diagnostic field. We have complete Diagnostic Service Facilities including Clinical laboratory, X ray, ECG and Ultra Sound Scan and has already earned the reputation of being best staffed, best equipped and fast growing diagnostic service centre, Kerala. All the results are released after strict scrutiny by our Quality Control Team. Our qualified technical staffs are well trained and they ensure stringent quality control for all the diagnostic services.
Speciality Diagnostic Centre
Test with Top Lab Equipment
Speciality Diagnostic Centre the first and only of its kind in Irinjalakuda, established in 2006 January has the full infrastructure and facilities for carrying out Laboratory investigations uitlising the most advanced technologies in the modern diagnostic field. We have complete Diagnostic Service Facilities including Clinical laboratory, X ray, ECG and Ultra Sound Scan and has already earned the reputation of being best staffed, best equipped and fast growing diagnostic service centre, Kerala. All the results are released after strict scrutiny by our Quality Control Team. Our qualified technical staffs are well trained and they ensure stringent quality control for all the diagnostic services.





